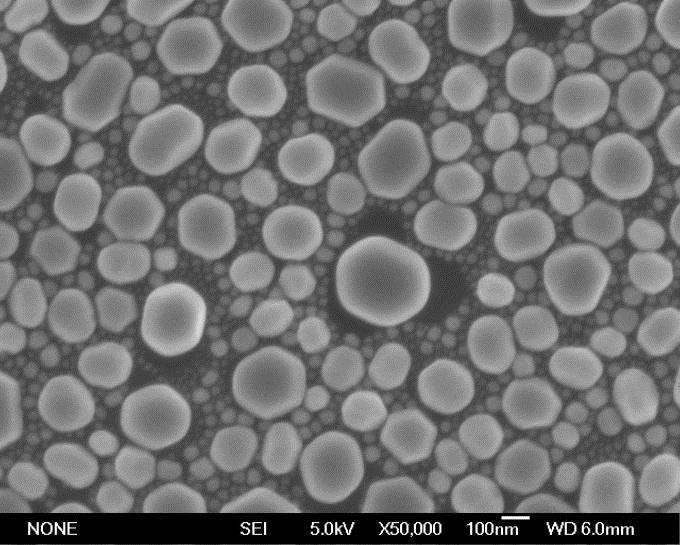
20201223171756.jpg

纳米铟粒子;球形铟粉;高纯金属铟
Indium
7440-74-6
7440-74-6
¥750
1件
起订
浙江 更新日期:2026-04-03
产品详情:
公司简介
浙江亚美纳米科技有限公司(以下简称“亚美纳米”)是一家专业致力于纳米粉体材料领域及其相关技术的研发、生产和销售为一体的高新技术企业。公司坐落于我国第一个县域经济示范区-浙江省嘉兴市嘉善经济技术开发区内,长期生产并经营:微纳米金属粉体、微纳米合金粉体、微纳米氧化物粉体、微纳米碳化物粉体、微纳米氮化物粉体、微纳米硫化物粉体、微纳米硼化物粉体、微纳米硅化物粉体、微纳米稀土氧化物粉体、单壁及多壁碳纳米管、石墨及石墨烯材料以及其他功能粉体......产品广泛应用于信息通讯、航空航天、军工、涂料、油墨、橡塑、陶瓷、纺织、化妆品、医药、电池、环保、太阳能等高科技领域。我们始终秉承“以技术创新为动力、以满足客户需求为使命”的经营理念,“锐意进取、诚实守信”的企业精神,紧随世界先进科技步伐,专注于纳米粉体和超细球形粉体应用技术开发。热忱欢迎各界人士加盟合作,共创纳米粉体材料领域的辉煌篇章!
| 成立日期 | (8年) |
| 注册资本 | 1000万 |
| 员工人数 | 50-100人 |
| 年营业额 | ¥ 5000万-1亿 |
| 经营模式 | 贸易,工厂,试剂,定制,服务 |
| 主营行业 | 纳米材料,金属和陶瓷材料,无机盐,无机化合物,高纯试剂 |
纳米铟粒子;球形铟粉;高纯金属铟相关厂家报价 更多
-
- 铟粉
- 武汉楚江浩宇化工科技发展有限公司 VIP
- 2026-04-03
- 询价
-
- 铟,7440-74-6,4N5铟锭
- 四川高纯材料科技有限公司 VIP
- 2026-04-03
- ¥5700
-
- 7440-74-6;铟
- 宝鸡福诺康实业有限公司 VIP
- 2026-04-03
- 询价
-
- 铟粉
- 雨木(宁波)新材料有限公司 VIP
- 2026-03-30
- 询价
-
- 铟 7440-74-6
- 湖北旋光科技有限公司 VIP
- 2026-03-05
- 询价
-
- 铟标准溶液
- 广州和为医药科技有限公司 VIP
- 2026-03-03
- 询价
-
- 高纯铟;6N铟;99.9999%铟
- 四川六族半导体材料有限公司 VIP
- 2026-02-28
- ¥1000
-
- 铟粉
- 安徽科润纳米科技有限公司 VIP
- 2026-02-24
- 询价
-
- 铟粉球形铟粉 高纯铟粉超细1-3um铟粉 微米铟粉9 9.9% In
- 宁波罗飞纳米科技有限公司 VIP
- 2026-02-14
- ¥530
-
- 球形铟粉
- 上海先芯新材料科技有限公司 VIP
- 2026-01-05
- 询价